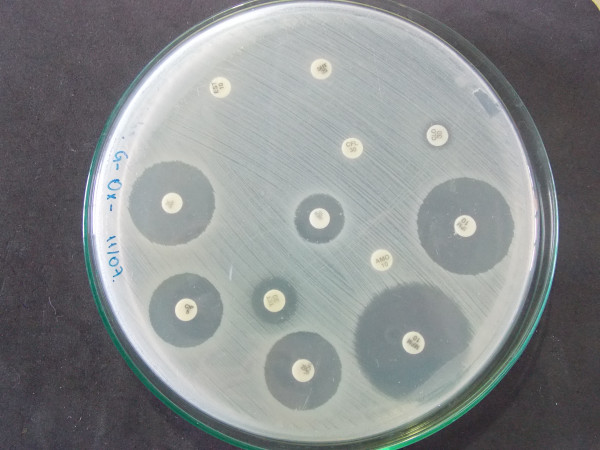
dscn0010

- Este endereço de email está sendo protegido de spambots. Você precisa do JavaScript ativado para vê-lo.
Laboratórios
434 Resultados
| Laboratório / Área / Categoria | |
|---|---|
Engenharias Laboratórios | |
Engenharias Laboratórios | |
 | Agrárias Laboratórios |
Engenharias Laboratórios | |
Exatas e da Terra Laboratórios | |
Exatas e da Terra Laboratórios | |
 | Engenharias Laboratórios |
 | Engenharias Laboratórios |
Agrárias Laboratórios | |
Agrárias Laboratórios | |
Biológicas Laboratórios | |
Agrárias Laboratórios | |
 | Saúde Laboratórios |
Saúde Laboratórios | |
Agrárias Laboratórios | |
| Agrárias Laboratórios |
 | Saúde Laboratórios |
 | Saúde Laboratórios |
 | Saúde Laboratórios |
Agrárias Laboratórios | |
Agrárias Laboratórios | |
Biológicas Laboratórios | |
 | Engenharias Laboratórios |
Engenharias Laboratórios | |
Engenharias Laboratórios | |
Engenharias Laboratórios | |
 | Sociais Aplicadas Laboratórios |
Biológicas Laboratórios | |
 | Biológicas Laboratórios |
Biológicas Laboratórios |
Página 10 de 15
